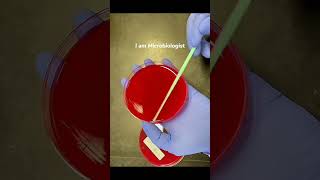
Agar plate streaking

Colony Forming Unit (CFU)
Enroll to start learning
You’ve not yet enrolled in this course. Please enroll for free to listen to audio lessons, classroom podcasts and take practice test.
Interactive Audio Lesson
Listen to a student-teacher conversation explaining the topic in a relatable way.
Introduction to CFU and Microbial Standards
🔒 Unlock Audio Lesson
Sign up and enroll to listen to this audio lesson

Today, we're going to discuss how we measure the number of microorganisms in water samples, specifically focusing on the concept of Colony Forming Units, or CFUs.

What exactly is a CFU, and why is it essential in microbiology?

Great question! A CFU refers to the number of viable bacteria in a sample that can form a colony. It helps us understand the population density of microorganisms, which is crucial for assessing water quality.

How are these CFUs counted in practice?

Typically, you take a water sample, culture the microorganisms on a nutrient medium, and after incubation, count the visible colonies that have formed. Remember, each CFU originates from a single bacterium!

I heard there are specific standards, like 5 per 100 ml. What do they signify?

Exactly! Those standards illustrate the acceptable concentration of microorganisms in drinking water, helping us determine its safety.

So, what happens when there are too many bacteria?

If there are too many, we may need to dilute the sample before counting, to ensure accurate CFU measurement. It’s all about obtaining distinct and countable colonies!

In summary, CFUs are vital for monitoring water quality, providing a clear index of microbial safety.
Challenges in Counting Microorganisms
🔒 Unlock Audio Lesson
Sign up and enroll to listen to this audio lesson

Now that we understand CFUs, let’s talk about the challenges in counting microbial populations.

What makes counting so difficult?

The main issue is that bacteria are tiny! With sizes around 1 to 10 microns, counting them directly is incredibly challenging—hence, we use filtration and microscopy.

And we need a microscope for that?

Correct! After filtering, we observe the filter under a microscope to identify the spots where bacteria have settled. It’s quite labor-intensive.

Are there alternative methods for this?

Yes! Techniques like flow cytometry help count cells as they pass through a laser, but these are not yet standard for water analysis due to sample representativeness issues.

What about distinguishing live from dead cells?

Distinguishing viable from non-viable cells is crucial because dead cells don’t pose health risks like pathogens do. We assess viability by cultured growth.

In short, while counting microorganisms is challenging due to sizes, techniques and viability assessment is essential for ensuring water safety.
Implications of Microbial Analysis
🔒 Unlock Audio Lesson
Sign up and enroll to listen to this audio lesson

Let’s wrap up by discussing the implications of microbial analysis in relation to public health.

Why should we care about microbial counts in water?

Waterborne pathogens can cause diseases, so high CFU counts can signal contamination. Monitoring helps protect public health.

How does turbidity relate to microbial analysis?

Great observation! High turbidity in water can indicate the presence of suspended microorganisms, which is a preliminary sign of contamination.

So directly culturing water is the best way?

Yes! Direct culturing tells us whether the bacteria are viable and can grow. It’s our most definitive testing method.

Overall, understanding microbial analysis is crucial for ensuring the safety of drinking water and public health.
Introduction & Overview
Read summaries of the section's main ideas at different levels of detail.
Quick Overview
Standard
The section covers the standards used in analyzing microorganisms, particularly the CFU method for counting bacteria in water, highlighting the challenges involved in this process, including the need for culturing and dilution techniques. It also mentions alternative methods such as flow cytometry and microscopy.
Detailed
In the section on Colony Forming Units (CFU), an essential measurement for analyzing microbial populations in environmental quality, particularly in water, is presented. The text explains that standards from organizations like the Central Pollution Control Board (CPCB) establish specific benchmarks (e.g., 5 microorganisms per 100 ml of water). Given the microscopic size of bacteria (1 to 10 microns), traditional counting methods require filtration and microscopy, which can be cumbersome. The section then describes a standard method involving culturing: taking a water sample, placing it on nutrient media, and incubating it to allow bacterial growth into visible colonies. This transformation from a single bacterium to a colony is referred to as a CFU. The need for dilution is also discussed, particularly when dealing with high concentrations, to ensure distinct colonies for accurate counting.
Further techniques such as flow cytometry and fluorescence microscopy are mentioned, alongside issues regarding representativeness in sample analysis. The significance of distinguishing viable (living) organisms from non-viable (dead) cells is emphasized given their implications for water safety and pathogenesis. The section concludes with a note on turbidity as an indirect measure of microbial presence in water, though asserts that culturing remains the most definitive method for confirming microbial viability.
Youtube Videos

Audio Book
Dive deep into the subject with an immersive audiobook experience.
Introduction to Colony Forming Unit (CFU)
Chapter 1 of 4
🔒 Unlock Audio Chapter
Sign up and enroll to access the full audio experience
Chapter Content
So, this is called as CFU or a colony forming unit. So, this takes around 24 hours. So therefore, you cannot get an immediate value of this thing, you have to take our sample put it on a nutrient medium, wait for 24 hours then you can see either directly or you can look at it under a microscope you can see this, you can see it and you can see directly, this is one way, there are other ways of doing it where you can look at it under a microscope.
Detailed Explanation
A Colony Forming Unit (CFU) represents a single viable microorganism that can grow and form a colony on a nutrient medium. The counting process involves taking a water sample and inoculating it onto a nutrient medium, where microorganisms that are present grow and multiply over about 24 hours. After this incubation period, the colonies that form can be counted, either by direct observation or with a microscope. This process is essential for determining the concentration of bacteria in the sample.
Examples & Analogies
Imagine baking a batch of cookies. You put a single dough ball on a baking tray, and once it's baked, it grows into a delicious cookie. Just like you can count how many cookies you made by looking at how many dough balls you started with, counting CFUs allows scientists to quantify the number of bacteria starting from a small sample.
Counting Microorganisms in Samples
Chapter 2 of 4
🔒 Unlock Audio Chapter
Sign up and enroll to access the full audio experience
Chapter Content
So, what if it has 100 already? If you have 100, you have no problem because there are other methods of doing it. But if you do culturing when you have very high concentration is you already have a lot of dots and this at the end of one day, you may get the big jumble, a big mass and you cannot differentiate how many originally were there. So, usually the analysis prefers that, if you have a very large number, you dilute it so that you can get distinct masses of colony forms.
Detailed Explanation
When a water sample presents a high concentration of microorganisms, counting individual colonies can become challenging because they overlap and form a mass. To accurately count the number of CFUs, dilution is carried out. For example, if you start with a sample that has 100 colonies, you would dilute it so you can count distinct colonies individually. After counting, the original concentration can be calculated by back-calculating using the dilution factor.
Examples & Analogies
Think of a crowded concert. If there are too many people packed together, it's hard to count each individual. However, if you split them into smaller groups, you can count each group and then multiply by the number of groups to find the total. Similarly, dilution allows scientists to simplify counting in dense microbial populations.
Techniques for Microbial Analysis
Chapter 3 of 4
🔒 Unlock Audio Chapter
Sign up and enroll to access the full audio experience
Chapter Content
So, microbes are treated like particles, so you can also look at it like a particle and look at it in a microscope and there are a lot of instruments now available, which use microscopy in order to count bacterial cells and these are not standard methods, but people use what is called as flow cytometry.
Detailed Explanation
Microbial cells can be viewed as particles, and advanced instruments like microscopes are utilized to count them. Flow cytometry is a technique that allows for counting and sorting cells based on their properties as they flow in a stream through a laser. Although it is useful, it is not yet a standard method for all microbial analysis because of issues concerning sample representativeness.
Examples & Analogies
Picture a busy street where cars pass through a toll booth, each counted by a machine. Flow cytometry acts similarly; as each microbial cell passes through the detector, it gets counted. This method offers quick results, but like the toll booth, it can be tricky if too many cars (or microbes) crowd together and distort the readings.
Staining and Fluorescence Microscopy
Chapter 4 of 4
🔒 Unlock Audio Chapter
Sign up and enroll to access the full audio experience
Chapter Content
So, people use other ways of detecting bacteria also which includes putting a dye something called a staining. They put a dye, this dye will go and absorb on different organisms in order to distinguish between which bacteria which fungus it is and then you can use what is called as a fluorescence microscope in order to detect and count.
Detailed Explanation
Staining is a technique where dyes are applied to microbial samples to enhance visibility under a microscope. These stains can specifically attach to certain types of bacteria or fungi, allowing for differentiation and better identification. Fluorescence microscopy takes this further by using fluorescent dyes that light up under certain wavelengths, making it easier to see and count the microorganisms in a sample.
Examples & Analogies
Imagine using highlighters to mark important passages in a book. Just as the highlighters make the text stand out, stains make the microbes more visible under a microscope, allowing scientists to identify various organisms in a sample efficiently.
Key Concepts
-
CFU: A unit used to estimate viable bacterial populations in a sample.
-
Viable vs Non-Viable: Distinction that helps understand potential health risks.
-
Turbidity: A preliminary indicator of microbial contamination.
-
Culturing Method: The technique for growing bacteria samples in a controlled environment.
Examples & Applications
If a water sample is plated and 10 colonies grow, this would indicate there were approximately 10 CFUs in that sample.
A turbidity increase in a water body may suggest microbial contamination, warranting further analysis.
Memory Aids
Interactive tools to help you remember key concepts
Rhymes
CFUs are a clue, for bacteria too; Count them right, to keep water bright!
Stories
Imagine a tiny bacterium, lost in a big ocean. It finds a warm nutrient plate, and with time, it grows into a colony of friends, showing how many CFUs were there!
Memory Tools
C – Colony, F – Forming, U – Units – Remembering CFU helps you measure viable bacteria easily.
Acronyms
Use CFU to Count the Fungi and Understand bacteria!
Flash Cards
Glossary
- Colony Forming Unit (CFU)
A unit used to estimate the number of viable bacteria in a sample, represented by the number of colonies that form from bacteria on a nutrient medium.
- Microorganisms
Minute living organisms, such as bacteria and fungi, that can only be seen under a microscope.
- Viable
Referring to living organisms capable of growth and reproduction.
- Nonviable
Describes organisms that are dead and cannot grow or reproduce.
- Turbidity
A measure of the cloudiness or haziness of a fluid as a result of suspended particles, indicating potential microbial contamination.
- Flow Cytometry
A technique that uses lasers to count and analyze the properties of individual cells in a fluid as they pass through a detection apparatus.
Reference links
Supplementary resources to enhance your learning experience.
